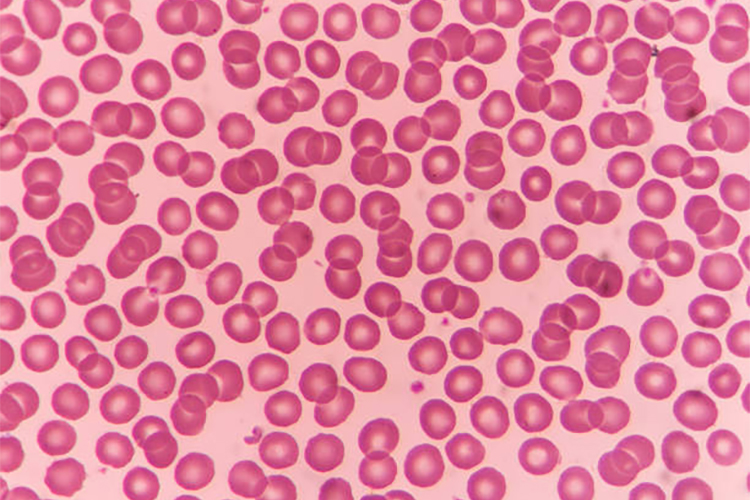

血细胞计数在医学诊断中起着至关重要的作用。传统的手工计数方法不仅耗时且易受人为误差影响。
项目信息
编号:MCV-5
大小:7.4M
运行条件
Matlab开发环境版本:
– Matlab R2020b
项目介绍
本研究设计并实现了一种基于MATLAB的自动血细胞计数系统。该系统利用图像处理技术,通过对血细胞图像的预处理、特征提取以及分类识别,实现了对红细胞的自动计数。具体而言,系统采用了自适应阈值分割、形态学操作和连通域分析等方法来精确分离和计数红细胞。
实验结果表明,该系统在不同图像环境下均能准确、高效地完成血细胞计数任务,有效提高了计数的准确性和效率。该系统的设计与实现为临床血液分析提供了一种可靠的自动化解决方案,具有重要的应用价值和广泛的推广前景。
项目报告
Tipps:设计报告Word格式,需要另外购买。
– 项目配套文档:设计报告

算法流程

代码讲解
Tipps:仅对XBJS_main.m部分代码简要讲解。该项目可以按需有偿讲解,提供后续答疑。







运行效果
– 运行blood_gui.m





项目文档
Tipps:可根据您的需要有偿文档撰写及文献翻译。
– 文档格式:WORD、PPT (后续免费修改服务)
– 文献翻译:中译英、英译中 (后续免费修改服务)
远程部署
Tipps:购买后可免费协助安装,确保运行成功。
– 远程工具:Todesk 、向日葵远程控制软件
– 操作系统:Windows OS
项目文件

文件目录
Tipps:完整项目文件清单如下:
项目目录
– 1.Code (完整代码:确保运行成功)
– 2.Result (运行结果:真实运行截图)
– 3.Demo (演示视频:真实运行录制)
声明:本站所有项目资源都可以正常运行,亲测无错!而且我们录制了演示视频,在我们注明的环境版本下,项目运行效果完全和演示视频一致。客服QQ:下载须知



评论(0)